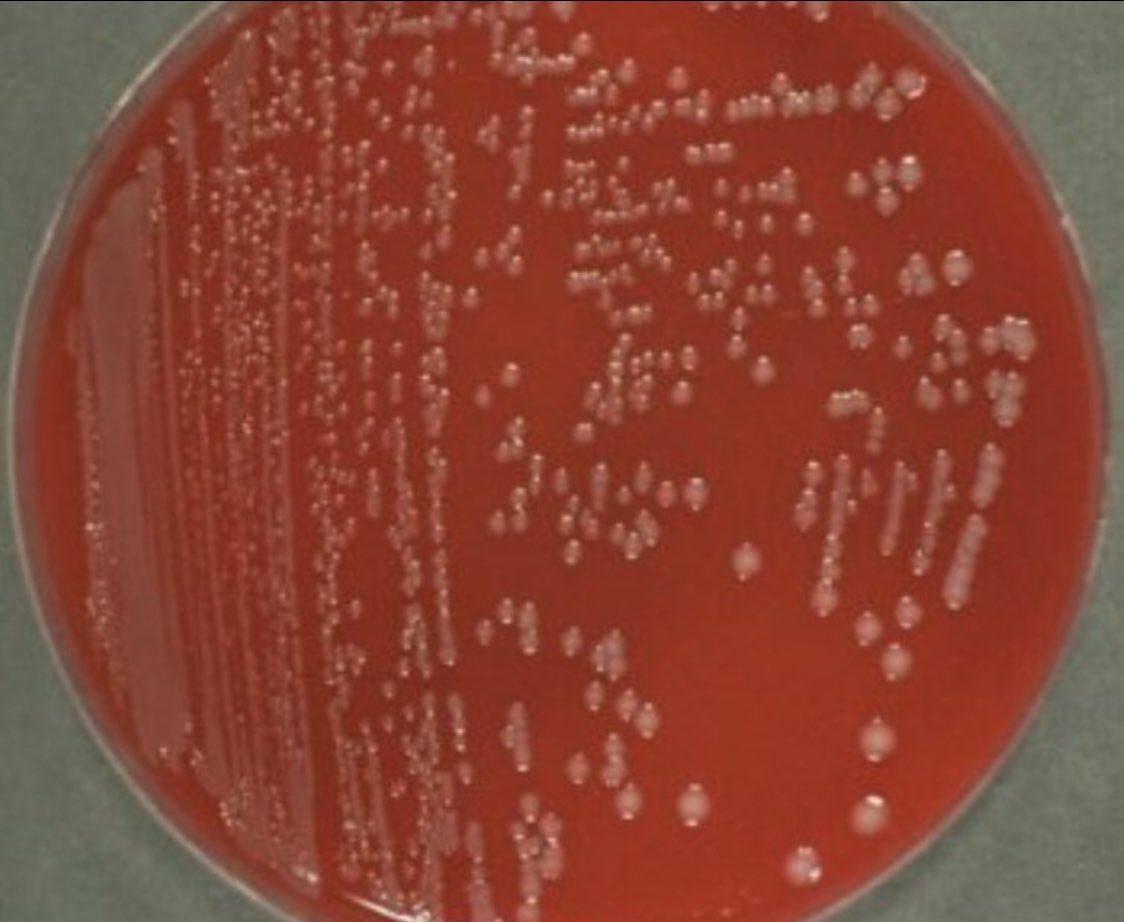
Indiana University Infectious Diseases Fellowship tweet media

#idfellow #idfellowship #infectiousdiseases #idmatch We matched! excited to welcome Rachel & Morgan! Follow us on insta & bluesky

English
Indiana University Infectious Diseases Fellowship
11.9K posts

@IUIDfellowship
@IUMedSchool @IUSMDeptMed #IDMedEd PD @sairabt APD @ecoleID #IDtwitter #IDBoardReview https://t.co/7UKjOqbPnb

🆕💫Ten Practical Tips for A Successful Presentation at Infectious Diseases Clinical Case Conference #IDXposts academic.oup.com/ofid/article/d…




















